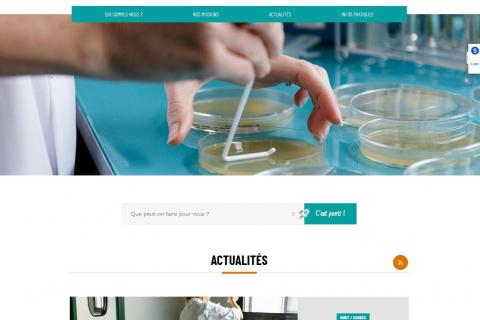
home laboratoire departemental d'analyses de l'aude

Culture
Actualités
Affichage des résultats 176 à 200 sur 904 au total
Routes
Poursuite du renouvellement du revêtement sur la RD 6009
Senior
2,7 M€ pour la reconstruction à neuf de l'Ehpad de Saissac
Unesco
Une étape déterminante franchie vers l'inscription au patrimoine mondial !
Patrimoine
Re-connexion-s à l'art contemporain et au patrimoine
Espaces naturels sensibles
Inauguration du sentier "des orchidées sur le chemin des planètes"
Agriculture durable
Le "Manger audois" au coeur de Prom'aude
Sport
L'album souvenir du passage de la flamme olympique !
Agriculture
Le laboratoire départemental gagne en visibilité avec son nouveau site web
Terroir
Toutes les saveurs du terroir à Prom'aude !
Tourisme
"L'Aude, l'âme sud" nouvelle identité touristique du département
Routes
Une fresque monumentale pour habiller la rocade Est
Education
Le collège de Grazailles sera rebaptisé... Simone Veil !
Culture
L'histoire au menu du Banquet de printemps
Solidarité
Une contractualisation solidaire signée avec le Sivom des Corbières
Culture
Une première convention d'objectifs pour le centre culturel de rencontre de Lagrasse
Département
La solidarité au menu d'un budget 2024 maîtrisé
Jeunesse
La Maison des ados veut continuer à grandir
Collèges
Bientôt un nouveau nom pour le collège de Grazailles
Sport
Prêts à décoller ? Rendez-vous au Mondial du Vent !
Aide aux communes
L'agence technique départementale aux côtés des communes depuis 10 ans
Culture
Henry de Monfreid une épopée exposée aux Archives
Environnement
Près de 140 rendez-vous pour (re) découvrir les richesses naturelles audoises
Aide sociale à l'enfance
Des maisonnées à taille humaine pour l'accueil d'urgence des enfants
Aménagement du territoire